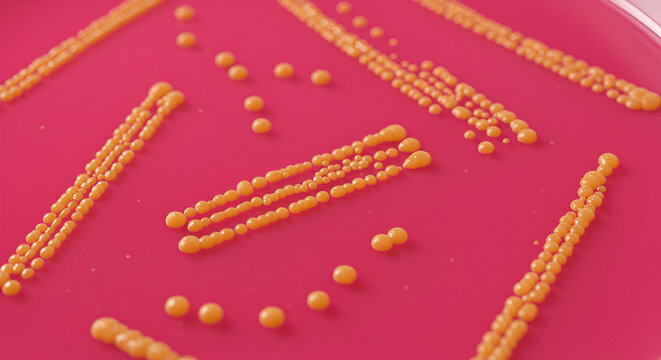
Staphylococcus Aureus Colonies on Mannitol Salt Agar &ndash; Diagnostic Microbiology

Bezpłatny okres próbny: otrzymasz 10 zdjęć stockowych oraz narzędzia do edycji oparte na SI
Bezpłatny okres próbny: otrzymasz 10 zdjęć stockowych oraz narzędzia do edycji oparte na SI
Dodano nowe filtry
Sortuj wg
350 wyników wyszukiwania „halobacteria” w kategorii: wszystko
Wyświetl halobacteria w kategorii Wideo (72)
Wybierz region
Wybór regionu może spowodować zmianę języka i treści promocyjnych na stronie usługi Adobe Stock.
Ameryka Północna
Ameryka Południowa
- Venezuela
- Algeria - English
- Armenia - English
- Azerbaijan - English
- Bahrain - English
- Belgium - English
- Belgique - Français
- België - Nederlands
- Česká republika
- Croatia - English
- Cyprus - English
- Danmark
- Georgia - English
- Deutschland
- Eesti
- Egypt - English
- España
- France
- Greece - English
- Iceland - English
- Ireland
Europa, Bliski Wschód i Afryka
- Israel - English
- Italia
- Jordan - English
- Казахстан
- Kenya - English
- Kuwait - English
- Киргизия
- Latvija
- Lebanon - English
- Lietuva
- Luxembourg - Deutsch
- Luxembourg - English
- Luxembourg - Français
- Mauritius - English
- Moldova - English
- Hungary - English
- Malta - English
- Morocco - English
- Nederland
- Nigeria
- Norge
- Oman - English